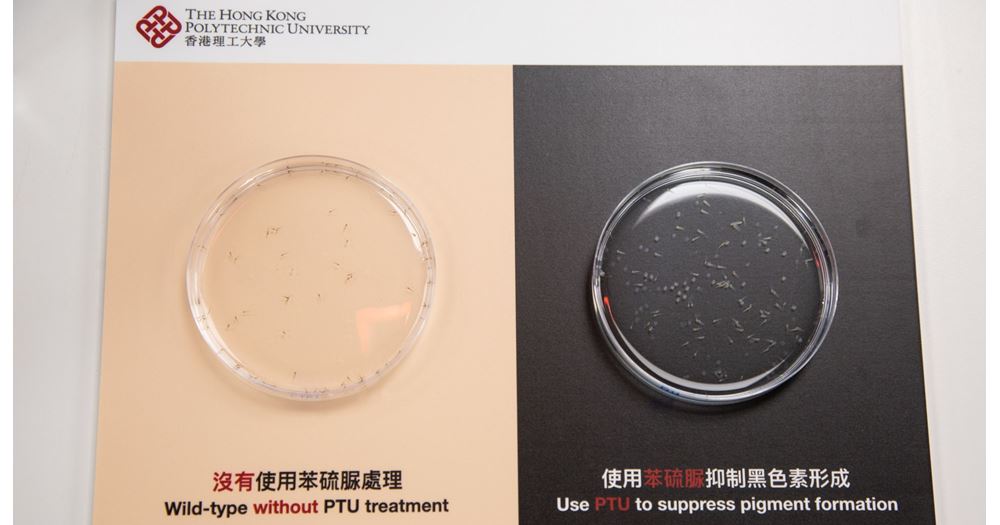

PolyU discovers the effect of chemical compound PTU on autophagy in zebrafish embryos, sheds light on cancer medication research
The zebrafish has been utilised as a model organism for biomedical research globally for half a century, mainly due to the high genetic similarity (over 70%) between zebrafish and human genes, with over 80% of human morbid genes related to at least one zebrafish orthologue. As test subjects, zebrafish are suitable for high throughput applications (to screen a large amount of genetic data simultaneously) and are widely used as a model organism for studying vertebrate development and for characterising diseases such as cancer, to help in identifying and testing new drugs. Fast development, cost-effective and easy to breed are also primary drivers for using the zebrafish research model. However, a recent research project led by Dr Alvin MA Chun-hang, Assistant Professor of the Department of Health Technology and Informatics, The Hong Kong Polytechnic University (PolyU), has revealed that the conventional application of 1-phenyl 2-thiourea (PTU), a pigment suppresser used in the zebrafish research model, may affect the results of autophagy-related studies. This ground-breaking finding subsequently sheds light on the respective research guidelines and the research protocol in on-going studies on autophagy and haematology, warranting researchers to re-examine research that is linked to existing cancer therapy options. The research titled “1-phenyl 2-thiourea (PTU) Activates Autophagy in Zebrafish Embryos” (link) was published in Autophagy, a peer-reviewed science journal in April 2020.
In most research using the zebrafish model, a chemical compound called 1-phenyl-2-thiourea (PTU) is commonly used to suppress pigment formation in zebrafish embryos, maintaining optical transparency to facilitate microscopic imaging. Over the past three years, the PolyU research team led by Dr MA has been using the zebrafish model to investigate the causes of leukaemia and its relationship with autophagy (self-eating) – a mechanism of metabolism that involves the degradation of cells by lysosomes and the process of cell renewal and regeneration. It is a cellular reaction to various physiological and pathological conditions regulating important processes, including intracellular material turnover, cell death, proliferation, development, ageing and tumourigenesis.
According to Dr Ma, “Upon 0.003% PTU treatment, aberrant autophagosome and autolysosome formation, accumulation of lysosomes and elevated autophagic flux were observed in various tissues and organs of the zebrafish,” He pointed out that “Autophagy is crucial in the process of drug resistance of various cells and over-activation of autophagy may potentially interfere with the efficacy of drugs. The research finding means that when we are using this prominent model to study any autophagy-related processes like cancer, the results may not be truly reflected. These studies could have produced skewed results. Researchers should avoid using PTU in autophagy-related research in the future.” Dr MA added that the team has already suspended the use of PTU in zebrafish research. Light-sheet microscopy, which offers greater imaging depth, will be employed as an alternative, for image autophagy in the zebrafish embryo with pigment for their study on leukaemia.
Furthermore, the new research findings also provide a direct mechanistic link between autophagy and melanoma, suggesting autophagy probably regulates melanoma development and drug resistance through interaction with tyrosinase, a key rate-limited regulator of melanin synthesis. Investigation into details of the molecular mechanism between autophagy and melanoma is expected in the future.
Professor YIP Shea-ping, Head of Department of Health Technology and Informatics, said, “We are pleased to see our research team’s recent discovery published in Autophagy, the highest impact journal in the field. Dr MA has also been invited as co-author for new guidelines on autophagy research using zebrafish embryos, a revision that takes place every four years. With the new guidelines in place, we will be able to modify the way we conduct autophagy-related studies with the zebrafish model and, hopefully, to open the door to new treatments for various deadly diseases.”
***** END *****
Press Contacts
Dr Alvin Ma Chun-hang
Department of Health Technology and Informatics
- 3400 8913
- alvin.ma@polyu.edu.hk
Press Contacts
Ms Ellena Kam
Communications and Public Affairs Office
- 3400 2128
- ellena.kam@polyu.edu.hk
You may also like